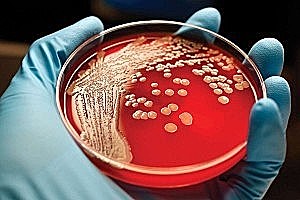
Los medios de cultivo.

-
Egipto: Antiguo testimonio de la polio.
Mesopotamia: "Toda enfermedad era un efecto de la voluntad divina de herir al pecador"
Roma: Fiebre de justiniano -
Fue una epidemia que afectó al Imperio romano de Oriente o Imperio Bizantino y otras partes de Europa, Asia y África, que se fue dando en diversos ciclos.
-
-
El ser humano conoce las actividades microbianas sin saber nada de los microorganismos
-
-
descubre accidentalmente el aumento producido por dos lentes convexas. Crea el primer microscopio compuesto. Se le atribuye la invención del telescopio.
-
-
Mircographia. Obra ilustrada sobre sus observaciones microscópicas, por primera vez usa la palabra "célula".
-
Describió algunos hongos filamentosos
-
Los infusorios (protistas en la clasificación zoológica moderna)
-
-
Las bacterias (por ejemplo, selenomonas grandes de la boca humana)
-
Los espermatozoides
-
El patrón de bandas de fibras musculare
-
Disputa entre John Needham(1748) y Lazzaro Spalllamzani(1765)
-
se convirtió en un afamado investigador, médico rural y poeta, cuyo descubrimiento de la vacuna antivariólica tuvo trascendencia definitoria para combatir la viruela. En el campo de la zoología, fue la primera persona en describir el parasitismo del cuco.
-
Usó calor para esterilizar. Calentó gases a través de un sistema abierto.
-
Utilizó KOH y H2SO4 concentrado. Pasó gases a través de una de las soluciones
-
Conocido como el "ángel de las parturientas" ó "el salvador de las madres" por sus estudios sobre la fiebre puerperal (1847)
El simple lavado de manos de médicos, enfermeras y parteras disminuyó notablemente la infección y la mortalidad entre las mujeres. -
Introdujeron el uso del algodón como filtro para evitar contaminación de los caldos. Pasaron aire a través de un tapón de algodón a un frasco que contenía un caldo previamente hervido y comprobaron que así se evitaba la aparición de microorganismos en el extracto.
-
Los hongos filamentosos mueren a 121ºC en calor humedo, pero sobreviven a 120ºC en calor seco.
-
Trampas para capturar microorganismos
Se pone fin a la controversia de la generación espontanea. -
Joseph Meister fue mordido por un perro con rabia, Pasteur decidió tratar al niño con el virus de la rabia debilitado. El tratamiento fue todo un éxito, el cual duró 10 días y consistió en varias inyecciones, gracias a las cuales el niño no murió.
-
-
Principios antisépticos en cirugía
-
Introdujo el uso de ácido carbólico (fenol) al 5% en las áreas de cirugía con el fin de minimizar las infecciones en los pacientes.
-
Luis Pasteur es llamado a Provenza para resolver la enfermedad del gusano de seda (pebrina)
en 1869 identifica el protozoario Nasema bombaycis como el responsable -
Ferdinand Cohn diseña los medios de cultivo con sales, extracto de levadura y diferentes azucares.
-
Diseña medios de cultivo con sales + extracto de levadura + diferentes azúcares
-
Con su técnica de cultivo puro (anéxico) aisla y propaga experimentalmente por primera vez una bacteria patógena (la responsable del carbunco o ántrax)
-
Las dos teorías sobre la forma de microrganismos: monomorfismo y pleomorfismo.
Su resolución dependió de los cultivos puros.
Robert Koch, con esta técnica, aísla y propaga la bacteria responsable del carbunco -
-
Robert Zoch colabora con la industria alemana de vidrio (Schott) y pide ayuda a expertos en óptica (Abbé, Zeiss)
-
Robert Koch.
Calor seco a 160º - 180ºC por 1.5 a 2 hrs.
Calor húmedo a 120ºC por 30 min -
-
-
-
Weisnegg fabricó la primera autoclave de laboratorio
-
Cohen describe la endospora bacteriana.
John Tyndall determina la existencia de: bacterias lábiles al calor, bacterias resistentes al calor -
En México, la vacuna antirrábica fue traída directamente de París por primera vez en 1888 por Eduardo Liceaga y producida en Ciudad de México y aplicada ese mismo año.
-
Primer aislamiento de una bacteria fijadora de nitrógeno.
explica el ciclo del N2 en la biosfera
Bacterias del hierro crecen en medios minerales. -
Bacterias del azufre oxidan sulfuros o S y obtienen energía de ello = quimiolitotrofía
-
Bacterias nitrificantes fijan CO2 con la energía de la oxidación del amonio o nitrato = quimiolito-autotrofía
-
En Alemania se inicia la producción de autoclaves para uso hospitalario
-
-
Se fundó el Instituto Antirrábico por iniciativa del Dr. Liceaga con el propósito de preparar y aplicar la vacuna pasteuriana
-
Investigó la fiebre maculosa de las montañas rocosas, demostró que la fiebre se transmitía por la picadura de una garrapata.
-
Considerado como "el padre de la Quimioterapia"
Descubrió la arsfenamina, que fue el primer tratamiento médico, diferente al mercurio eficaz contra la sífilis, creando el moderno concepto de quimioterapia. -
Ricketts y wilder anunciaron el descubrimiento de un microorganismo, aparentemente un bacilo, en la sangre de pacientes con tifus y en el insecto.
-
-
Obtención del extracto crudo de penicilina (del hongo Penicillium notatum). Inicia la era de los antimicrobianos.
-
Fue el primer antibiótico empleado en medicina y su descubrimiento es atribuido a Alexander Fleming.
Obtención del extracto crudo de penicilina(del hongo Penicillium noatum) -
Purificación de la penicilina. Uso en la 2da Guerra Mundial.
-
Descubrimiento de la estreptomicina de Streptomyces griseus, capaz de eliminar el bacilo tuberculoso.
Tras la guerra, se descubren numerosos antibióticos, producidos sobre todo por Actinomicetos. -
Watson y Crick publicaron la famosa estructura de la doble hélice del DNA.
La Doble Hélice del DNA es uno de los más grandes descubrimientos científicos de todos los tiempos. -
La viruela (del latín variola: pústula pequeña) fue una enfermedad infecciosa grave, contagiosa y con un alto riesgo de muerte, causada por el virus Variola virus.1 El último caso de contagio natural se diagnosticó en octubre de 1977 y en 1980 la Organización Mundial de la Salud (OMS) certificó la erradicación de la enfermedad en todo el planeta.
-
El equipo del Instituto Pasteur de París, Jean-Luc Montagnier, anuncia el descubrimiento del Virus de Inmunodeficiencia Humana (VIH).
-
Warren JR y Marshall BJ revolucionan el entendimiento de varias patologías gástricas, al encontrar este bacilo curvo no identificado en el epitelio gástrico, en gastritis crónica activa.
-
Craig Venter y el premio Nobel Hamilton Smith, dos de los científicos que más contribuyeron a la elaboración del mapa del genoma humano, anunciaron ayer su intención de crear vida en el laboratorio. En concreto pretenden crear un organismo con tan sólo aquellos genes que son absolutamente necesarios para la vida, a partir del ser vivo que funciona con menos genes, el Mycoplasma genitalium.
-
Virus altamente patógeno de origen asiático.
Se detectó por primera en seres humanos, en medio de un brote originado en aves de corral en Hong Kong. -
Es una neumonía muy grave, causada por un nuevo virus de la familia de los coronavirus.
El primer caso de SARS se declaró en Hanoi (Vietnam). -
En la primavera del 2009, surgió un nuevo virus de la influenza A (H1N1). Fue detectado primero en los Estados Unidos y se propagó rápidamente por todo el país y el resto del mundo. Este nuevo virus H1N1 contenía una combinación exclusiva de genes de virus de influenza que nunca antes había sido identificada en personas o animales. Este virus fue designado como virus de la influenza A (H1N1)
-
l virus de la influenza A subtipo H7N3 es un subtipo de la especie del virus de la influenza A. En América del Norte, la presencia de H7N3 se confirmó en varias granjas avícolas en Columbia Británica en febrero de 2004; los rebaños fueron sacrificados para detener la propagación del virus
-
La enfermedad por el virus del Ebola (EVE) es un enfermedad grave, a menudo mortal en el ser humano. El virus se detectó por vez primera en 1976 en dos brotes simultáneos ocurridos en Nzara (hoy Sudán del Sur) y Yambuku (República Democrática del Congo). La aldea en que se produjo el segundo de ellos está situada cerca del río Ebola, que da nombre al virus.
-
Es un virus que apareció en China, después se extendió a todos los continentes del mundo provocando una pandemia.
Looking for a timeline maker?
Create timelines for projects, roadmaps, history, lessons, legal cases, and stories with Timetoast. Timetoast is a timeline maker for work, school, research, and stories.